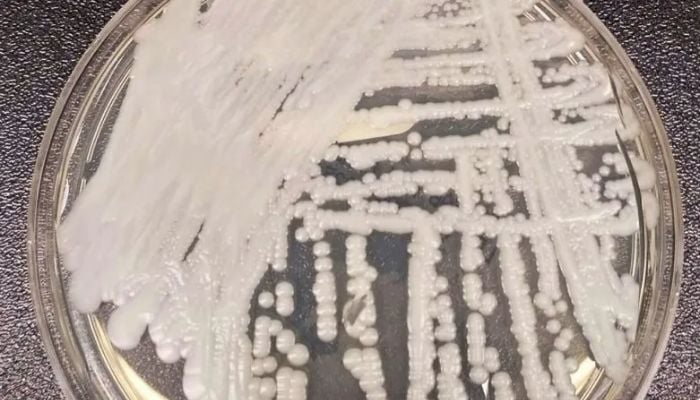
‘Superbug’ fungus infections approach record high in US

‘Superbug' fungus infections approach record high in US
Published December 31, 2025
A drug-resistant and often deadly fungus is spreading at an alarming rate across U.S. healthcare facilities.
Centers for Disease Control and Prevention (CDC) unveils that at least 7,000 infections reported so far across 27 states.
The pathogen named, Candida auris, is classified by the CDC as an “urgent threat” due to its resistance to most antifungal medications and its high mortality rate in vulnerable patients.
The virus was first identified in the U.S. in 2016, it preys on individuals in hospitals and nursing homes, spreading through contaminated surfaces, catheters, and medical equipment.
This year’s data is estimated to cross the 2024’s record of over 7,500 infections.
The fungus poses little threat to healthy individuals but can be fatal for those with weakened immune systems.
Earlier data indicated that around 30%-60% of infected patients have died, though many had other serious illnesses.
Scientists also indicate to a disturbing link with climate change. As global temperatures rise, fungi like C. Auris may be adapting to survive warmer temperature. Fungi are reportedly breaking through the “temperature barrier” that once protected humans.
Health officials note stringent infection control in clinical settings as the superbug continues to challenge the nation’s public health defenses.











